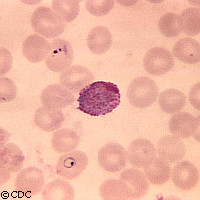

Neue Malaria-Schwachstelle entdeckt
Europäische Forscher sind seit langem auf der Suche nach einer Möglichkeit, der potenziell tödlich verlaufenden Malaria, die in den Entwicklungsländern noch immer nicht erfolgreich bekämpft werden konnte, endgültig Einhalt zu gebieten. Nun hat man im Zuge neuer Untersuchungen einen der Tricks herausgefunden, mit denen sich diese Krankheit vor unserem Immunsystem tarnt. Matthew Higgins vom Department of Biochemistry an der Universität Cambridge, UK, konnte diesen bei seinen Untersuchungen entlarven. Seine Ergebnisse wurden im "Journal of Biological Chemistry" veröffentlicht. Malaria ist wahrscheinlich die tödlichste aller parasitären Krankheiten. Einigen Forschern zufolge sterben etwa zwei Millionen Menschen pro Jahr daran. In vielen Entwicklungsländern, wo die Krankheit am meisten verbreitet ist, haben manche Menschen eine Teilimmunität gegen Malaria entwickelt, nachdem sie viele Male von ihr heimgesucht worden waren. Doch leider stellt diese Teilimmunität keinen Schutz für sie dar. Stattdessen kann die Krankheit verschiedene Gestalten annehmen oder diese Immunität dahingehend ausnutzen, dass sie sich vor Medikamenten tarnt, die sie eigentlich ausschalten sollen. So ist die Krankheit geschützt, die Infektion jedoch hält an. Dies kann dazu führen, dass eine noch bösartigere Form dieser Krankheit entsteht, da sich schließlich die infizierten Zellen im Gehirn sammeln und eine zerebrale Malaria verursachen. Die Plazenten von Schwangeren sind besonders anfällig für Malaria, da sie der Krankheit ein neues Ziel zum Einlagern infizierter roter Blutkörperchen bieten. Schätzungen zufolge sterben auf diese Weise jährlich 75.000 bis 200.000 Föten. Viele weitere Babys, die diesen Angriff im Mutterleib überleben, haben dann ein geringes Geburtsgewicht. Malariaparasiten bzw. Plasmodien werden über infizierte Stechmücken auf den Menschen übertragen. Sobald sich die Parasiten im menschlichen Wirt befinden, wandern sie sofort zur Leber und greifen dort die Zellen an. Nach diesem ersten Anschlag dringen sie in die roten Blutkörperchen (RBK) ein, um sich dort zu vermehren, und warten dann auf die nächste Stechmücke, die weitere Hilfe für die Aufrechterhaltung dieses Kreislaufs bringt. Dr. Higgins untersuchte nun das Malaria-Protein PfEMP1 (Plasmodium falciparum erythrocyte membrane protein 1), das auf der Oberfläche infizierter roter Blutkörperchen zu finden ist. Er entdeckte einen variablen Abschnitt dieses Proteins, der sich über den Bereich des Proteins erstreckt, der für die Einlagerung der roten Blutkörperchen in die Plazentawand verantwortlich ist. Wenn die nächste Welle infizierter Blutkörperchen die Wand erreicht, wandert der variable Abschnitt zur Seite. Dann liegt für einen ganz kurzen Zeitraum die Schnittstelle bzw. der Ankerplatz frei, so dass sich die infizierten Blutzellen dort selbst fixieren können. Auf der Grundlage dieser Entdeckung können neue Medikamente entwickelt werden, mit denen diese Schwachstelle ins Visier genommen und ausgenutzt wird. Arzneimittel, die sich als Chondroitinsulfat tarnen und den besagten Abschnitt freilegen, könnten einen praktikablen Ansatz darstellen, mit dem die körpereigene Immunität schneller aufgebaut wird. Aufgrund seiner Untersuchungen kann Dr. Higgins ein Modell vorstellen, mit dem er aufzeigt, wie dieser Teil des Proteins dem Parasiten bei der Umgehung der Immunabwehr hilft. Mit diesen Informationen kann die künftige Medikamenten- und Impfstoffentwicklung vorangetrieben werden. Für seine Arbeiten stand ihm teilweise die Bildgebungstechnik der Europäischen Synchrotron-Strahlungsanlage (ESRF) zur Verfügung.
Länder
Vereinigtes Königreich